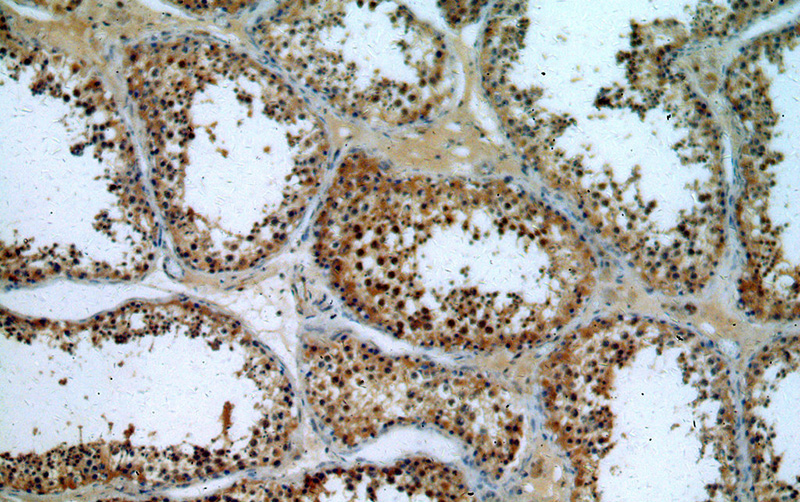
Immunohistochemical of paraffin-embedded human testis using Catalog No:112792(MTOR antibody) at dilution of 1:50 (under 10x lens)

-
Product Name
MTOR antibody
- Documents
-
Description
MTOR Rabbit Polyclonal antibody. Positive WB detected in HeLa cells, HeLa/RPE1 cells, K-562 cells, MCF7 cells. Positive IP detected in HeLa cells. Positive IHC detected in human testis tissue, human prostate cancer tissue. Positive IF detected in HeLa cells. Observed molecular weight by Western-blot: 289 kDa
-
Tested applications
ELISA, WB, IHC, IP, IF
-
Species reactivity
Human,Mouse,Rat; other species not tested.
-
Alternative names
FLJ44809 antibody; FRAP antibody; FRAP1 antibody; FRAP2 antibody; Mammalian target of rapamycin antibody; MTOR antibody; RAFT1 antibody; Rapamycin target protein 1 antibody; RAPT1 antibody
-
Isotype
Rabbit IgG
-
Preparation
This antibody was obtained by immunization of Peptide (Accession Number: NM_004958). Purification method: Antigen affinity purified.
-
Clonality
Polyclonal
-
Formulation
PBS with 0.02% sodium azide and 50% glycerol pH 7.3.
-
Storage instructions
Store at -20℃. DO NOT ALIQUOT
-
Applications
Recommended Dilution:
WB: 1:200-1:2000
IP: 1:200-1:2000
IHC: 1:20-1:200
IF: 1:20-1:200
-
Validations

WB result of anti-mTOR (Catalog No:112792) in different cell lysates.

HeLa cells were subjected to SDS PAGE followed by western blot with Catalog No:112792(MTOR antibody) at dilution of 1:500
Immunohistochemical of paraffin-embedded human testis using Catalog No:112792(MTOR antibody) at dilution of 1:50 (under 10x lens)

Immunohistochemical of paraffin-embedded human testis using Catalog No:112792(MTOR antibody) at dilution of 1:50 (under 40x lens)

IP Result of anti-MTOR (IP:Catalog No:112792, 5ug; Detection:Catalog No:112792 1:500) with HeLa cells lysate 1200ug.

Immunofluorescent analysis of HeLa cells using Catalog No:112792(MTOR Antibody) at dilution of 1:50 and Alexa Fluor 488-congugated AffiniPure Goat Anti-Rabbit IgG(H+L)
-
Background
MTOR, also named as FRAP1, FRAP, FRAP2 and RAPT1, belongs to the PI3/PI4-kinase family. MTOR is a Ser/Thr protein kinase that functions as an ATP and amino acid sensor to balance nutrient availability and cell growth. MTOR is Kinase subunit of both mTORC1 and mTORC2, which regulate cell growth and survival in response to nutrient and hormonal signals. mTORC1 is activated in response to growth factors or amino-acids. mTORC2 is also activated by growth factors, but seems to be nutrient-insensitive. mTORC2 seems to function upstream of Rho GTPases to regulate the actin cytoskeleton, probably by activating one or more Rho-type guanine nucleotide exchange factors. mTORC2 promotes the serum-induced formation of stress-fibers or F-actin. The antibody is specific to MTOR.
-
References
- Luo W, Wang X, Zheng L. Brucine suppresses colon cancer cells growth via mediating KDR signalling pathway. Journal of cellular and molecular medicine. 17(10):1316-24. 2013.
- Zhao L, Teng B, Wen L. mTOR inhibitor AZD8055 inhibits proliferation and induces apoptosis in laryngeal carcinoma. International journal of clinical and experimental medicine. 7(2):337-47. 2014.
- Kang GH, Lee BS, Lee ES, Kim SH, Lee HY, Kang DY. Prognostic significance of p53, mTOR, c-Met, IGF-1R, and HSP70 overexpression after the resection of hepatocellular carcinoma. Gut and liver. 8(1):79-87. 2014.
- Zhang Y, Zhan Y, Zhang D. Eupolyphaga sinensis walker displays inhibition on hepatocellular carcinoma through regulating cell growth and metastasis signaling. Scientific reports. 4:5518. 2014.
- Li X, Zou K, Gou J. Effect of baicalin-copper on the induction of apoptosis in human hepatoblastoma cancer HepG2 cells. Medical oncology (Northwood, London, England). 32(3):72. 2015.
- Liu M, Xu L, Yin L. Potent effects of dioscin against obesity in mice. Scientific reports. 5:7973. 2015.
- Tan L, Wei X, Zheng L. Amplified HMGA2 promotes cell growth by regulating Akt pathway in AML. Journal of cancer research and clinical oncology. 142(2):389-99. 2016.
- Wang L, Wang C, Jia Y, Liu Z, Shu X, Liu K. Resveratrol Increases Anti-Proliferative Activity of Bestatin Through Downregulating P-Glycoprotein Expression Via Inhibiting PI3K/Akt/mTOR Pathway in K562/ADR Cells. Journal of cellular biochemistry. 117(5):1233-9. 2016.
Related Products / Services
Please note: All products are "FOR RESEARCH USE ONLY AND ARE NOT INTENDED FOR DIAGNOSTIC OR THERAPEUTIC USE"
